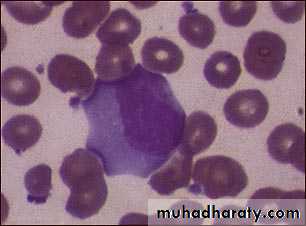

Pharynx
Dr. Basil M.N. SaeedAssistant Professor
Department of Surgery
College of Medicine
Mosul University
Pharynx
Is a funnel-shaped fibromuscular tube,10-12 cm in length in adults.
Extends from the base of the skull to the level of C6.
The pharynx is divided
anatomically into 3 parts; Nasopharynx
Oropharynx
Laryngopharynx
(( Hypopharynx))
Behind :
The NoseThe Mouth
The larynxNasopharynx
OropharynxLaryngopharynx
(Hypopharynx)
Seen from behind
Nasopharynx(( Postnasal Space))
This extends from the base of the skull to the hard palate.At the junction of the roof and posterior wall lies a small mass of lymphoid tissue called adenoids (nasopharyngeal tonsil).
On the lateral wall, there are the openings of the Eustachian tubes.
Behind which are hollows called the fossa of Rosenmuller, which is the site of nasopharyngeal malignancy
-Communicates inferiorly with the oropharynx through the velo-pharyngeal sphincter
Oropharynx
Extends from the level of hard palate to the level of hyoid bone and opens anteriorly into the oral cavity. Behind the oral cavity (in front of 2nd&3rd Cervical vertebra)The palatine tonsils are situated in it's lateral wall
Between the ant. and post tonsillar pillars.
From the soft palate
superiorly to tip ofepiglottis inferiorly
Communicates:
Anteriorly with
the oral cavity
Superiorly with the
nasopharynx
Inferiorly with
the hypopharynx
Hypopharynx
Behind the Larynx (in front of 3rd to 6th Cervical vertebra)From the tip of epiglottis
superiorly tothe lower border
of cricoid cartilage
inferiorly
Communicates:
Anteriorly with the Larynx
Superiorly with the oropharynx
Inferiorly with the esophagus
The hypopharynx does not only
lie behind the larynx BUT alsoProjects laterally on each side of the larynx and is formed of :
Postcricoid region
( behind the larynx)
Two pyriform fossae
(on each side of the larynx
Pharyngeal Wall Histology
Wall HistologyThe pharyngeal wall consists of 4 layers:
1. Mucous membrane.
2. Pharyngobasilar fascia.
3. Muscle layer.
4. Buccopharyngeal fascia.
1- Mucus Membrane
The lining epithelium is stratified squamous except in the nasopharynx, where columnar epithelium is found.2- Pharyngobasilar fascia
This fascia is strengthened posteriorly by a strong band called the median raphae.3- Muscular Layer
I- Circular (outer): which consist of 3 constrictor muscles overlapping one another from below upwards.
1. Superior constrictor.
2. Middle constrictor.
3. Inferior constrictor.
• The inferior constrictor muscle is composed of 2 parts:
• a. Thyropharyngeus (oblique): arises from the thyroid cartilage.
• b. Cricopharyngeus (transverse): arises from the cricoid cartilage and passes transversely backwards forming the upper oesophageal sphincter.
• All the constrictor muscles are inserted posteriorly into the median pharyngeal raphae.
Functions
The constrictor muscles propel the bolus of food down into the esophagusThe Cricopharygeus (lower fibers of the inferior constrictor) act as a sphincter, preventing the entry of air into the esophagus between the acts of swallowing
Killian dehiscence: this is a potential gap between the fibers of the thyropharyngeus and cricopharyngeus. The mucous membrane may bulge between these two muscles when there is incoordination of the pharyngeal peristaltic waves.
Pharyngael Pouch
• II- Longitudinal (internal): these muscles elevate the larynx and shorten the pharynx during deglutition:
• 1. Stylopharyngeus.
• 2. Salpingopharyngeus.
• 3. Palatopharyngeus
Buccopharyngeal Fascia
This fascia is loosely attached posteriorly to the prevertebral fascia and laterally connected to the styloid process and to the carotid sheath
Subepithelial lymphoid tissue of the pharynx (Waldeyer's ring)
Is a collection of sub-epithelial lymphoid tissue around the entrance of the respiratory and alimentary tracts.Waldeyer's ring is formed by
• 1. Nasopharyngeal tonsil (adenoid).• 2. Tubal tonsils: lie behind the openings of the Eustachian tubes.
• 3. Palatine tonsils.
• 4. Lingual tonsils: which is embedded in the posterior 1/3 of the tongue.
• 5. Lateral pharyngeal bands behind the posterior tonsillar pillar.
• 6. Lymphoid nodules scattered on the posterior pharyngeal wall
Hypertrophy of the lymphoid tissue of Waldeyer's ring occurs in the earlier years of childhood.
Maximum bulk is obtained at the age of 3- 6 years, and in old age it atrophies
• Waldeyer's ring is characterized by:
• 1. Sub-epithelial lymphoid tissue.
• 2. Lack a definite capsule.
• 3. They have efferent lymph vessels, but no afferent vessels.
• 4. Function as one unit: when a member of it is removed, the others parts undergo compensatory hypertrophy.
Palatine Tonsils
Two masses of lymphoid tissue situated on each side of the oropharynx.The medial surface is exposed in the pharynx and is pitted by a number of crypts.
The tonsil is related anteriorly and posteriorly to the palatoglossus and palatopharyngeus muscles.
Laterally the tonsil is enclosed by a dense fibrous capsule separating the tonsil from the superior constrictor muscle (tonsillar bed).
This capsule provide a convenient plane of separation of the tonsil during tonsillectomy
Palatine tonsil
The main supply is the tonsillar branch of the facial artery, and decsending palatine artery.
The venous drainage is to the paratonsillar vein which drains to the pharyngeal plexus, and the internal jugular vein.
Lymphatic Drainage
Deep cervical chain of lymph nodes.
Blood Supply of the Tonsil
Sensory Nerve Supply
Nasopharynx: Maxillary nerve, trigeminalOropharynx: Glossopharyngeal nerve, trigeminal
Laryngopharynx: vagus nerve, and glossopharyngeal.
Motor supply
All the muscles of pharynx, except the stylopharyngeus, are supplied by the pharyngeal plexus.
Pharyngeal branches of the IX and X nerves, and sympathetic fibers from the superior cervical ganglion.
The stylopharyngeus is supplied by the glossopharyngeal nerve
Nerve Supply of the Pharynx
This space lies behind the pharynx and extends from the base of the skull to the superior mediastinum.The anterior wall is formed by the posterior pharyngeal wall and it's covering buccopharyngeal fascia.
The posterior wall is formed by the cervical vertebrae and their covering muscles and fascia.
Retropharyngeal Space (Space of Gillette)
Contents:
Retropharyngeal lymph nodes of Rouviere.
Usually disappear
spontaneously during the
3rd or 4th year of life.
This potential space lies lateral to the pharynx and connects posteriorly with the retropharyngeal space.
It extends from the base of the skull to the hyoid bone.
It's bounded medially by the superior constrictor muscle.
Laterally lies the medial pterygoid muscle, the mandible and the parotid gland.
It's posterior wall is the prevertebral muscles and fascia.
Parapharyngeal Space
Contents
1. Deep cervical lymphnodes.2. The last 4 cranial nerves and the cervical sympathetic trunk.
3. Great vessels of the neck: carotid and internal jugular vein.
Parapharyngeal space
Parapharyngeal space
• 1. Food and air inlet.
• 2. Play an important role in speech through vocal resonance and articulation.• 3.The protective function of Waldeyer's ring.
• 4. Deglutition: it's divided into 3 stages:
• a. Oral stage (voluntary).
• b. Pharyngeal stage (involuntary).
• c. Oesophageal stage (involuntary).
Physiology of the Pharynx
1- Sore throat (pain)
a. Inflammatory.b. Neoplastic.
c. Neurological: IX neuralgia.
d. Blood dyscrasia: agranulocytosis and leukaemia.
2- Dysphagia: is difficulty in swallowing whereas odynophagia is painful swallowing.
Dysphagia: Intraluminal, Luminal , Extraluminal
3- Difficulty in breathing like stridor in Ludwig's angina.
4- Difficulty in speech: Paralysis of the soft palate(hypernasalily).
5- Neck mass Cervical lymphadenopathy
Symptoms of Pharyngeal Diseases
Examination
Nasopharynx: This can be done with postnasal mirror and tongue depressor (posterior rhinoscopy), and it can be thoroughly examined by rigid and flexible endoscopes.Oropharynx: It is simple with tongue depressor; palpation may be needed for the tongue.
Hypopharynx: It can be done with the use of laryngeal mirror to examine the larynx too. It can be done thoroughly with the use of endoscope.
Neck examination: for cervical lymphadenopathy.
Other areas : ears are examined for secretory otitis media in cases of nasopharyngeal tumours.
Investigations of pharyngeal diseases
Radiography:Plain films like lateral X-Ray of the skull, is needed in nasopharyngeal mass like adenoids, and can demonstrate bone erosion in cases of nasopharyngeal cancer.
Contrast films: barium swallow is needed in the diagnosis of pharyngeal pouch, esophageal web and hypopharyngeal mass.
CT scan
MRI scan.
Laboratory investigations:
CBC, ESR, serum iron and iron binding capacity, monospot test, serology for toxoplasma, brucella, CMV and HIV.
Biopsy for suspected lesions in the pharynx may be needed.
• Is an inflammation of the whole lining of the oral cavity.
• It could be:
• -Viral infection: Herpes simplex
• -Bacterial: Gingivitis.
• -Fungal: candidiasis (thrush).
• -Spirochaetes: Vincent's angina.
• -Miscellaneous: Aphthus, Behcets syndrome, pemphigus and pemphigoid.
Stomatitis
Recurrent oral ulceration of unknown aetiology:
viral, psychogenic, endocrinal and autoimmune.Clinical picture
This ulcer is typically quite sensitive and painful, has a central necrotic base with a surrounding red circumference.
Two types:
The minor form, more common, 3-6 mm in size and multiple and heal within 7-10 days without leaving a scar.
The major form, 1-2 cm in size, less common, long lasting and heal with a scar.
Aphthus Ulcer
Treatment
Is symptomatic:-Oral antiseptic: like chlorhexidine gurgle.
-Topical application of local analgesic like xylocaine.
-Topical steroids e.g. Kenalog in orabase.
It is a gingivitis producing ulceration and necrotic membrane.
It is called "Trench Mouth"Aetiology
Infection : Spirochaete, Borrelia vincenti & an Anaerobic organism , Bacillus fusiformis.
Occurs in debilitated patients who have poor dental hygiene.
Fever, sore throat , tender LN.
Acute necrotizing gingivitis (Vincent's angina)
On examination
The lesions originate around the interdental papillae and gums and may spread to involve the tonsil and oropharyx. The ulcers are painful, associated with foeter (fishy odor), and covered by a slough.Diagnosis
Swab for gram stain and culture.Treatment
-Oral hygiene by mouth wash.
- Antibiotics like benzyl penicillin + metronidazole.
Acute cellulitis of the floor of the mouth and submandibular space secondary to soft tissue infection.
Infection within a closed fascial space, tension rises rapidly and laryngeal oedema may occur.
Aetiology
Root abscess of the lower premolar and molar teeth (80%).The most usual organisms are strepto. viridans and E. coli.
-Tonsillar infection.
-Submandibular sialadenitis
Ludwig's Angina
Clinical picture
The patient is ill, toxic > 38 oC with odynophagia and salivation.
On examination
Indurated and usually non-fluctuant swelling below the angle of the jaw.
The floor of the mouth becomes very oedematous with the tongue pushed upwards.
• Potential complications
• -Airway compromise due to laryngeal oedema.• -Spread into the parapharyngeal and retropharyngeal spaces.
• -Septicaemia.
• -Aspiration pneumonia.
Treatment
-Early stages (early cellulitis): heavy antibiotics covering aerobes and anaerobes.-Drainage: If the state progress and the swelling increases.
Curved incision 2 cm below the angle of the jaw.
-Endotracheal intubation and
tracheostomy may be required
if laryngeal oedema
supervenes.
Acute pharyngitis
Acute inflammation of the mucous membrane of the pharynx occurring primarily in winter months.Aetiology
Viral in origin( mostly adenovirus and rhinovirus).
20 % are bacterial: mostly Pneumococci, Haemophilus influenza and group A beta-hemolytic streptococci (S. Pyogens).
30 % No pathogen is isolated.
Pharyngitis may be part of the clinical picture of measles, scarlet fever, infectious mononucleosis and typhoid fever.
Pharyngitis
Symptoms-Sore throat, Chills, Pyrexia, Headache and Joint pain.
Sings
-Redness and injection the mucous membrane of the pharynx.
-Hypertrophic and proliferation of lymphoid tissue on the posterior pharyngeal wall with particular aggregates in the lateral pharyngeal bands.
- Oedema of uvula
-Tender and palpable cervical LN.
Treatment
-Symptomatic: bed rest, analgesics and fluid by mouth.-Antibiotics: if bacterial infection is suspected.
Generalized inflammation of the mass of the tonsil, usually accompanied by a degree of inflammation of the pharynx.
Any age group, most frequently found in children.
Aetiology
Bacteria :group A B-haemolytic streptococcus, pneumococcus, staphylococcus& Haemophilus influenzae.
Viruses: rhinovirus, adenovirus &
enterovirus
Acute Tonsillitis
• Symptoms
• Onset: often sudden :• -Sore throat & odynophagia.
• -Constitutional symptoms especially in children.
• -Referred otalgia and abdominal pain due to mesenteric adenitis.
• Examination
• - Furred tongue & halitosis.
• - Tonsils: enlarged red and swollen.
• -The crypts become filled with pus (follicular tonsillitis).
• - A patchy membrane on the surface of the tonsil (membranous tonsillitis).
• -Cervical tender lymphadenopathy jugulodigastric node.
Acute follicular tonsillitis
• Differential Diagnosis• -Scarlet fever: Streptococcal infection erythrogenic toxin.
• Tongue has a strawberry appearance
• Cutaneous punctate erythema.
• -Glandular fever:
• -Agranulocytosis and leukaemia.
• -Acute diphtheria.
• -Vincent's angina.
Scarlet fever
• Complications
• local• a. peritonsillar abscess(quinsy).
• b. Retropharyngeal abscess.
• c. Parapharyngeal abscess.
• d. Acute otitis media.through the Eustachian tube.
• General
• a. Rheumatic fever and glomerulonephritis which follow B- haemolytic streptococcal tonsillitis of Lancet group A.
• b. Subacute bacterial endocarditis.
• c. Septicaemia.
Treatment
1. Bed rest, good oral fluid intake.
2. Antipyretics and analgesics.
3. Antibiotics: Penicillin, Erythromycin in allergy to penicillin.
Lack of response may suggest the presence of B-lactamase producing organism or even an anaerobic one, in which augmentin and/or metronidazole will be the antibiotic of choice.
Peritonsillar Abscess( Quinsy)
Is a collection of pus between the fibrous capsule of the tonsil and the superior constrictor.Usually unilateral, Adult males.
Complication of acute tonsillitis.
Clinical Picture
1. The patient looks ill, feverish with rigor .2. Acute sore throat & referred otalgia, Odynophagia). This makes the saliva dribbles from the month.
3. Trismus: irritation of the pterygoid muscles .
4. Thick and muffled voice often called “hot potato
voice”.
Examination
1. The tonsil is congested and pushed medially with the soft palate bulging downward and forward.
The uvula may be pressed against the opposite tonsil.
2. Red and enlarged anterior tonsillar pillar.
3. Tender and enlarged cervical lymph nodes
.
Treatment
I. Medical : Effective in early peritonsillar cellulitis.II. Surgical : when considerable swelling is present or in case of failure to medical treatment.
1. Incision of the abscess: this is undertaken at the point of maximum swelling of the soft palate. The classical site is at a point where an imaginary line through the base of the uvula is intersected by a perpendicular line from the junction of the anterior tonsillar pillar with the tongue.
The tonsils might be removed 6-8 weeks following quinsy.
2. Abscess tonsillectomy
Membranous Pharyngitis
• -Viral infection: infectious mononucleosis.• -Bacterial: diphtheria and scarlet fever.
• -Fungal: candidiasis.
• -Spirochaetes: Vincent's angina.
• -Blood dyscrasia: agranulocytosis and leukaemia.
Infectious Mononucleosis
Is a systemic infection by Epestein Barr virus which spread by droplets transmission. It is a disease of young adults and characterized by an increase in atypical lymphocytes.
Clinical picture
-Anorexia and low grade fever.
-Sore throat associated with odynophagia.
-Pharyngeal congestion with superficial ulceration of the tonsils. Red spots may appear on the palate.
-Generalized lymphadenopathy.
-Spleenomegaly.
Investigation
1. CBP increase in atypical lymphocytes (mononuclear cells).2. Positive Paul-Bunnell and monospot tests.
Treatment
Is non specific
1. Antipyretics & analgesics.
2. Antibiotics play no role in treatment and ampicillin is not given as it may cause skin rash.
Diphtheria
Is a specific infection by Corynebacterium diphtheriae which is disseminated by droplets.Children are mostly affected with a mortality of 10%.
Clinical picture
The patient is severely ill, although the temperature seldom rises above 38 oC.
The disease is characterized by the appearance of a membrane on the tonsils, soft palate and posterior pharyngeal wall.
The disease may spread to affect the nasal cavities and nasopharynx.
The membrane is usually grey in colour, firmly attached to the mucosa and leaves a bleeding surface when it's removed.-Tender and enlarged cervical lymph nodes.
• Investigation
• Swab for bacteriological examination including part of the membrane.
• Complications
• -Laryngeal obstruction and stridor tracheostomy.
• -Myocarditis and neuritis.
• The exotoxin produced by the microorganism is toxic to the heart and nerves.
• Neuritis is in form of paralysis of soft palate and ocular muscles.
Chronic Tonsillitis
Usually follows acute or subacute attacks of tonsillitis.More common in children between the age of 4-15 years.
There is a chronic inflammatory hypertrophy, usually associated with adenoid enlargement.
Clinical picture:
Persistent or recurrent sore throat.Persistent cervical adenitis.
Marked tonsillar enlargement with congested anterior pillars.
Treatment is usually surgical( tonsillectomy ) if symptoms persist.
Tonsillectomy
Indications for tonsillectomy
1. Recurrent attacks of acute tonsillitis.2. Peritonsillar abscess (quinsy).
3. Sleep apnea syndrome.
4. Tonsillectomy for biopsy purposes.
Others:
Diphtheria carriers.
Recurrent attacks of otitis media ??
Acute rheumatic fever and acute glomeluronephritis if streptococcus tonsillitis has been responsible for recurrence
Contraindications
1. Bleeding disorders or clotting problems.2. Acutely inflamed tonsil and recent upper respiratory tract infection.
3. Epidemic of poliomyelitis: fatal bulbar paralysis
4. Cleft palate: tonsillectomy leads to scarring of the soft palate which affects repair and speech.
Postoperative care
• 1. Nursing of patient in tonsillectomy position.• 2. Careful monitoring of vital signs.
• 3. Analgesia: paracetamol. NSAID should be avoided.
• 4. Encourage the patient to move the muscles of the throat by swallowing, talking and dinking: shedding of the slough from the tonsillar fossa allowing healing to take place.
Complications
1. Haemorrhagea. Primary: Recent infection, previous quinsy or severe scarring. Excessive bleeding from both fossae :coagulation defect.
Blood transfusion may be necessary.
b. Reactionary haemorrhage, within 24 hours. Preparing blood and early return to the theatre.
c. Secondary: Occurs some 5-8 days after the operation. It's due to infection.
Readmission to the hospital and a course of antibiotics is ordered.
2. Trauma: Teeth are at risk during tonsillectomy. Insertion of the mouth gag can lead to dislocation of the TMJ.
3. Infection: Prolongation of the pyrexia is a sign of infection which if untreated may lead to secondary haemorrhage.
4. Otitis media: should be distinguished from referred otalgia.
5. Chest complications: URTI at the time of operation or due to inhalation of blood or broken tooth.
Chronic irreversible inflammation of the mucous membrane of the pharynx with hyperplasia of it's various elements.
The normal lymphoid tissue on the posterior pharyngeal wall undergo hypertrophy so called granular pharyngitis.
The strip of lymphoid tissue in the posterior tonsillar pillar may undergo an overgrowth forming the lateral pharyngeal band.
Chronic Pharyngitis
Aetiology
Usually obscure:-Recurrent attacks of acute
pharyngitis.
-Persistant neighbourhood
infection as chronic sepsis in
the sinuses, teeth, and gums.
Bronchiactasis is said to be associated with chronic pharyngitis.
-Exogenous irritants such as tobacco, alcohol and industrial fumes.
-Endogenous irritants as gastroesophageal reflux.
-Allergic factors.
Clinical picture
1. Sorethroat , no constitutional symptoms and the condition persists for weeks or months.2. Foreign body sensation in the throat and tendency to clear the throat, which results from postnasal drip bathing the posterior pharyngeal wall.
3. Tiring of voice (not hoarseness).
ExaminationSimple (catarrhal) type: redness and congestion of the pharyngeal mucosa. The uvula may appear enlarged or elongated.
Hypertrophic (granular) type: small nodules are scattered on the posterior pharyngeal wall giving a granular appearance. The lateral pharyngeal bands may be prominent.
Treatment
• 1.Treat the cause:• Sinusitis, allergy, and GERD.
• 2. Avoidance of irritants: smoking, alcohol, and food.
• 3. Reassurance by the exclusion of malignancy.
• 4. Soothing gargles.
• 5. Antibiotics in acute exacerbation and fever.
Adenoids
The adenoids lie between the roof and posterior wall of the nasopharynx.
Adenoids differ from tonsillar tissue in that it's bounded by no capsule, contains no crypts and covered by ciliated epithelium.Hypertrophy of the nasopharyngeal tonsil, sufficient to produce symptoms, most commonly between 3-7 years of age.
Symptoms
A-Nasal- Nasal obstruction, mouth breathing, snoring , in severe cases: OSA.
- Persistent nasal discharge & postnasal drip. The child may be described as " always having a cold".
- Nasal speech (rhinolalia clausa).
B- Aural
Recurrent attacks of otitis media and otitis media with effusion.C-General
Failure to thrive, mental dullness.Pharyngitis and recurrent URTI
Examination
I. Adenoid facies.1. Open mouth.
2. Prominent upper
incisor teeth.
3. Short upper lip.
4. Narrow nostrils.
5. Hypoplastic maxilla.
6. High arched palate.
7. Dull expression due to hypoxia and deafness.
2. Mucoid and mucopus discharge from the nose with postnasal catarrh.
3. Posterior rhinoscopy and fibroptic endoscopy: lobulated mass, which occasionally extends laterally.Investigations
X-ray of the postnasal spaceComplications
1. Persistent snoring and sleep apnea syndrome.2. Recurrent URTI.
3. Recurrent attacks of acute otitis media and otitis media with effusion.
4. Orthodontic disturbances.
5. Speech problems (rhinolalia clausa).
6. Failure to thrive in infants.
Treatment
1. Conservative: in mild symptoms bya. Treatment of allergy and sinusitis.
b. Local nasal steroids.
2. Surgical: if no response to medical treatment by
Adenoidectomy
Contraindications
1. Cleft palate.
2. As tonsillectomy
Complications
1. Haemorrhage (Primary, reactionary or secondary): Post nasal pack is inserted under G.A. , may be blood transfusion.2. Trauma to the uvula, soft palate and
Eustachian cushions.
3. Hypernasality(Rhinolalia aperta):
It occurs in case of submucosal cleft palate or after excessive scaring of the soft palate.
4. Incomplete removal and recurrence.
A chronic atrophic type of inflammation of the mucous membrane of the pharynx. The major changes occur in the postcricoid region initially started by fissuring and hyperkeratosis followed by fibrosis, web formation of stricture.
A small proportion of patients (3%) with this condition progress to the stage of postcricoid cancer.
Aetiology
It’s unknown but autoimmune and metabolic basis may be presumed.
Paterson-Kelly Syndrome (Plummer Vinson)
• Clinical picture• -Common in females usually over 40 years.
• -Dysphagia and feeling of a lump in the throat.
• -Pallor due to iron deficiency anaemia.
• -Fissures at the angles of the mouth result from angular stomatitis.
• -Dryness of the tongue because of glossitis .
• -Loss of weight
Angular stomatitis Glossitis
• Investigations
• -Haematological: CBP---- hypochromic microcytic anaemia, low serum iron and high iron binding capacity.• -Ba -swallow: web at the
• postcricoid region.
• -Endoscopy: changes of the
• Postcroid
• region.
• Treatment
• -Iron and vitamin B complex in high doses.• -Endoscopic dilation in resistant cases to medical treatment to relieve dysphagia and exclude malignancy ( by histopathological examination).
• -Keep the patient under observation, because malignant changes can still occur.
Sensation of a lump in the throat affecting mainly females, which is brought on or made worse by anxiety.
Aetiology
The condition is often regarded as functional in which no other organic cause can be found.
Recently the most accepted organic theory is gastroesophageal reflux.
Globus Hystericus (Globus Pharyngeus)
Clinical Picture
Sensation of a lump in the throat, which is, noticed when the patient is swallowing saliva and relieved by meals.There is no true dysphagia and the patient often has psychological stress or cancer phobia.
• Diagnosis
• The condition should not be diagnosed until an organic lesions has been excluded in order not to miss an early carcinoma.• -Ba -Swallow ---- cricopharyngeal spasm
• -Endoscopy to exclude any abnormality
• -Full haematological investigations
• Treatment
Reassurance that there is no organic disease or cancerAntireflux therapy: Omeprazole + Domperidone
Psychiatric consultation is required in selected cases
An abscess in the potential space between the buccopharyngeal and prevertebral fascia. There are two distinct types.
Collection of pus in the retropharyngeal space due to infection in the retropharyngeal lymph nodes (lymph nodes of Rouviere).
Retropharyngeal Abscess
Acute Retropharyngeal Abscess
Parapharyngeal space: orange
Retropharyngeal space: blueAetiology
-Upper respiratory tract infection (Tonsillitis, sinusitis)-F.B penetrating the posterior pharyngeal mucosa.
Clinical Picture
Mostly affects infants and it's of acute onset
1. The patient is ill, toxic and feverish.
2. Sore throat with pain and discomfort on swallowing and the patient may drool saliva.
3. Nasal obstruction in upward situated abscess and laryngeal obstruction (stridor) in those situated downward
Examination
-Swelling on one side of the posterior pharyngeal wall.
-Cervical lymphadenopathy.
Investigations
Lateral X-ray of the neck, which shows increase in prevertebral soft tissue shadow or an air-fluid level.
Retropharyngeal space
Acute retropharyngeal abscess
Retropharyngeal abscess
Treatment
Under the cover of intravenous antibiotics, the abscess should be drained vertically through the posterior pharyngeal wall.1. Drainage under G.A. with endotracheal tube.
2. If no facility for G.A. an assistant should be ready to turn the patient over quickly after drainage to avoid inhalation of pus. A sucker should be present to aspirate the pus.
• This is caused by TB of the cervical spine.
• Clinical Picture• Occurs in older children, adolescents and adults. It’s of slow onset and presents as:
• -Pharyngeal discomfort rather than pain.
• -Mild dysphagia.
Chronic Retropharyngeal Abscess (Potts Abscess)
Examination
1. Painless swelling on the posterior pharyngeal wall.2. Enlarged and painless cervical lymphadenopathy.
Investigations
Lateral X-ray of the neck shows evidence of bone destruction and loss of the normal curvature of the cervical spine.
Treatment
1. Drainage through the neck and never through the mouth to avoid secondary infection.
2. Full anti T.B. therapy must be ordered.
Chronic retropharyngeal abscess
• A suppurative infection of the parapharyageal space.• Aetiology
• -Complication of tonsillitis or tonsillectomy.
• -Infection or extraction of the lower third molar tooth.
• -Extension of mastoid infection
Parapharyngeal Abscess
• Clinical Picture
• Occurs mostly in adolescents and adults• -The patient is feverish , ill and toxic.
• -Acute sore throat with trismus because of spasm of the medial pterygoid muscle .
• Examination
• -Tender and firm swelling in the upper part of the neck.
• -The pharyngeal wall and tonsil are pushed medially.
Parapharyngeal Abscess
Complications
1- Acute oedema of the larynx tracheostomy.2. Thrombophlebitis of the IJV with septicaemia.
3. Carotid artery erosion.
4. Cranial nerves and sympathetic chain involvement leading to Horner,s syndrome.
5. Spread of infection into the mediastinum.
Treatment
Antibiotics should be commenced before culture and sensitivities are available:
I.V. penicillin + Metronidazole
If the general condition is stable and airway is patent investigations can be done:
1. WBC ↑, ESR ↑2. Needle aspiration will prove the diagnosis( if doubtful) and pus is send for culture.
3. Orthopantomogram ( OPG) may shows root abscess.
4. Ultrasound of the neck can differentiate between cellulites and abscess collection.
If there is no improvement within 24 hours abscess must be drained:
Under GA and ETT collar incision is done in the neck at the level of hyoid bone at the anterior border of sternomastoid muscle, pus is evacuated and drain is inserted.
Nasopharynx
Benign: Angiofibroma (Most common)
Papilloma
Haemangioma
Craniopharyngioma
Malignant: Nasopharyngeal carcinoma
Adenocarcinoma
Fibrosarcoma
Rabdomyosarcoma
Tumours of the Pharynx
Oropharynx
Benign: PapillomaMalignant: Epithelial: squamous cell cacrcinoma
Lymphoma: Hodgkin's and non- Hodgkin's
Salivary gland: Adenocystic carcinoma
Hypopharynx
Benign: Fibrolipoma and leiomyoma
Malignant: Squamous cell carcinoma (pyriform fossa, postcricoid posterior pharyngeal wall).
Is a vascular tumour of the nasopharynx occurring almost entirely in adolescent males (7-19 years with a mean of 14 years. The tumour has a tendency to regress after puberty. Although the tumour is benign, but it is locally invasive and behaves as malignant.
Juvenile Nasopharyngeal Angiofibroma
Aetiology
The exact aetiology is unknown but various theories have been postulated.1. Hormonal theory based on that it is a tumour of males.
2. Remnants of embryonic tissue.
3. Hamartoma or paraganglioma.
Pathology
The tumour takes origin from the periosteum on the lateral wall of the nasopharynx close to the sphenopalatine foramen . Extension occurs:
1. Anteriorly to the nasal cavity and ethmoid.
2. Superiorly to the base of the skull.
3. Laterally to the pterygoid fossa, maxillary antrum and orbit.
Pathology
Microscopically, the tumour consist of vascular spaces abounding in a stroma of fibrous tissue. The vascular spaces consist of thin-walled sinusoidal vessels unsupported by a muscular coat. This account for the severe bleeding as the vessels loose the ability to contract.Clinical Picture
The patient is nearly always a young boy with a mean age of 14 years.1. Repeated attacks of epistaxis which can be extremely profuse due to absence of muscular coat from the sinusoids.
2. Progressive nasal obstruction.
3. Conductive deafness occurs from pressure on the Eustachian tubes.
Examination
1. Endoscopy and posterior rhinoscopy: smooth, rubbery lobulated mass in the nasopharynx.
2. Middle ear effusion.
3. Mass in the nasal cavity or on the cheek if the tumour has extended anteriorly or laterally.
4. Proptosis results from extension of the tumour to the
orbit through the
infraorbital
fissure.
Investigation
1. Imaging:a. X-ray of the base of the skull and a lateral view of the skull.
b. CAT scan, MRI and MRA.
c. External carotid arteriography.
2. Biopsy is contraindicated because of fatal
bleeding.
Differential Dx
Antrochoanal
polyp.
2. Nasopharyngeal
carcinoma
Treatment
1. Surgical excision Haemorrhage is the main danger of operation, so adequate blood should be prepared before the operation.2. Embolization is indicated preoperatively to control the vascularity of the tumour.
3. Radiotherapy should be reserved for patients with inoperable intracranial extension and recurrent tumours.
This tumour is common in south east Asia especially in China.
Nasopharyngeal CarcinomaAetiology
Is exactly unknown1-Viral: Epestain-Barr virus has been suggested as a cause, but the exact role is unknown.
2. Genetics: Chinese have a high genetic susceptibility. Chinese population who move to western countries retain a high incidence suggesting a genetic predisposition.
3. Environmental factors: common in southern China.
a. Ingestion of salted fish.
b. Indoor cooking in homes without Chimneys
Pathology
Most tumours arise from the fossa of Rosenmuller. In endemic areas undifferentiated carcinoma is the mostcommon histological type.
• Spread of Nasopharyngeal Carcinoma
• Direct, lymphatic (cervical L.N.) and blood borne (rare)
• -Anteriorly into the nasal cavity and paranasal sinuses leading to nasal symptoms.
• -Posteriorly to the retropharyngeal space and lymphnodes of Rouviere.
• -Laterally into the parapharyngeal space involving the last 4 cranial nerves.
• -Superiorly through the base of skull involving the optic nerve and the cavernous sinus.
• -Inferiorly to the oral cavity and retrotonsillar region
Spread of NP Carcinomma
Clinical Picture
Bi-modal age distribution with the first age peak at 2nd decade and the other peak at 5th – 7th decade of life. It affects males more than females-Cervical lymphadenopathy : is often the presenting feature which may be unilateral or bilateral.
-Nasorespiratory symptoms : nasal obstruction, nasal speech and
epistaxis.
-Tinnitus and aural symptoms due to Eustachian tube obstruction. This may proceed to secretory otitis media.
-Neurological symptoms : the most frequently involved nerves are V, VI, IX and X. The latter 2 nerves paralysis lead to immobility of the soft palate.
Involvement of the
sympathetic chain results
in Horner,s syndrome.
-Pain and headache due
to intracranial extension or sphenoidal sinusitis
Examination
1. Endoscopy and posterior rhinoscopy.one may see a large exophytic tumour but a small tumour may be missed.
2. The palate is pushed downward and paralyzed.
3. The neck should be palpated for metastatic lymphnodes.
4. Middle ear effusion.
5. Parapharyngeal spread can cause trismus.
Investigation
1. Imaging:a. X-ray of the base of the skull---- bony destruction involving the petrous bone, foramen lacerum and carotid canal.
b. CT scan and MRI: MRI is superior to CT scan in finding soft tissue involvement.
2. Biopsy under G.A.
Treatment
1. Radiotherapy is the treatment of choice because surgical removal of the primary growth is rarely possible.2. Chemotherapy as an adjuvant to radiotherapy is of contraverse issue.
3. Surgery in form of radical neck dissection is reserved for patients with persistent or recurrent neck disease following radiotherapy.